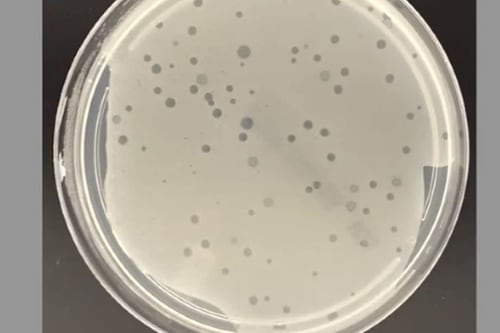
Resistencia a antibióticos: ¿Qué son los virus depredadores que combaten bacterias?

antibióticos
‘Es una enfermedad horrible’: Aumentan casos de tos convulsiva en niños y adolescentes de EU
La tos ferina, también llamada tos convulsiva, suele afectar sobre todo a lactantes y niños pequeños, quienes pueden llegar a desarrollar complicaciones graves.
Buenas, nuevas: Analizan uso de antibiótico para prevenir ETS
La doxiciclina tiene beneficios demostrados en la reducción clamidia, gonorrea y sífilis, señalan los CDC.
Cofepris alerta sobre el uso de medicamentos con cefalosporinas: ¿Qué pacientes no deben usarlos?
La Cofepris analizó medicamentos con cefalosporinas, un antibiótico de amplio espectro.
Esto sabemos de la bacteria ‘devoradora de carne’ y por qué es tan letal para el ser humano
Las infecciones causadas por la Vibrio vulnificus son raras y más graves que la mayoría de las demás.
Resistencia a antibióticos: ¿Qué son los virus depredadores que combaten bacterias?
Cada año se registra cerca de un millón de muertes a nivel mundial debido a la resistencia antimicrobiana.
Candida auris: Esto debes saber del hongo mortal resistente a medicamentos que se expande en EU
Los casos de Candida auris han crecido exponencialmente desde finales de 2021, según análisis médicos.
¿Te pueden amputar alguna extremidad si solo tienes gripe? Esto dicen expertos
¿En qué situaciones se puede agravar una gripe o una infección al punto de perder alguna extremidad?
Trasplantes fecales: ¿Qué son y cómo pueden ‘salvar’ la microbiota intestinal?
En el trasplante fecal, las heces derivadas de donantes seleccionados deben ser procesadas y preparadas antes de trasplantarlas al receptor.
Resistencia a los antibióticos: ¿qué podemos hacer ante esta amenaza sanitaria?
No todas las bacterias son resistentes a los antibióticos, pero hay al menos seis de gran preocupación.
Infección en vías urinarias: ¿Cuáles son los síntomas, las causas y cómo tratarla?
¿Cómo saber si tengo una infección en vías urinarias?